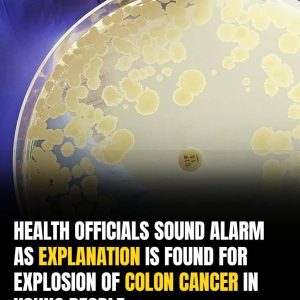

Oral Can.cer: Symptoms You Shouldn’t Ignore.
Our mouths are not only the gateway to our bodies, but also a reflection of our overall health. Many diseases and deficiencies can manifest themselves through oral…
Surinam toad
The Surinam toad is this one. Babies emerge from a collection of tiny holes in their mother’s back in one of the most bizarre birth practices in…

If you see 8 signs, go for an early check-up
Can:cer often develops silently, with early symptoms easily overlooked. One major area of concern is unexpected changes in bathroom habits. These subtle shifts may point to serious…

8 SYMPTOMS OF ESOPHAGEAL CAN.CER YOU SHOULD NEVER IGNORE
Esophageal ca-ncer is a serious condition that often goes unnoticed in its early stages. Recognizing the symptoms early can greatly improve the chances of successful treatment. Here…

I Chew Cloves And Say Goodbye to 10 Years of Diabetes.. I’ll Give You The Recipe
Cloves are well-known for their use in fruit-based sweets like banana and pumpkin desserts, but their versatility extends far beyond. Around the world, cloves season preserves, sauces…

A new type of Artificial Intelligence can detect breast cancer 5 years before diagnosis
AI is changing the game in cancer care—big time. New tools can detect breast cancer up to five years before a clinical diagnosis, giving doctors a powerful…

6 Essential Vitamins Every Woman Should Consume After 50 to Reduce Can.cer Ri.sk
After age 50, many women experience changes like joint pain, slower metabolism, and reduced energy. These are natural shifts, but they highlight the importance of proactive health…

Do your hands or joints hurt? Do this immediately and say goodbye to pain!
Joint and hand pain are common and often treated with over-the-counter medications, but frequent use can lead to side effects. Thankfully, natural remedies like turmeric offer relief…
Alarming Rise In Colon Cancer Among Young People May Be Linked To Contaminated Salad, Study Finds
Alarming Rise in Colon Cancer Among Young People Linked to Contaminated Salad, Study Finds A sharp rise in early-onset colon cancer may be linked to a dangerous…

Important Signs To Look For That Could Suggest You Have Polymyalgia Rheumatica
Here’s a shorter, clear summary of your text: Polymyalgia Rheumatica: What to Know Polymyalgia rheumatica (PMR) is an inflammatory condition causing muscle and joint stiffness, mainly in…